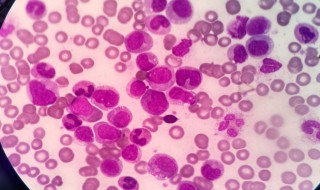
中性粒细胞百分比低怎么办 有问题吗

1、出现这种情况是否有一些明确的表现,比如说存在有呼吸系统的表现,或者是消化系统的表现,您目前的情况考虑存在有中性粒细胞偏低,淋巴细胞偏高的情况,大多数的原因是由于病毒感染等因素引起的。部分类型的病毒感染,有可能可以自行痊愈。具体还要看原因
2、建议可以适当服用些双黄莲口服液或三九感冒灵等抗病毒的感冒药治疗即可
健康养生2022-03-24 00:51:06未知
1、出现这种情况是否有一些明确的表现,比如说存在有呼吸系统的表现,或者是消化系统的表现,您目前的情况考虑存在有中性粒细胞偏低,淋巴细胞偏高的情况,大多数的原因是由于病毒感染等因素引起的。部分类型的病毒感染,有可能可以自行痊愈。具体还要看原因
2、建议可以适当服用些双黄莲口服液或三九感冒灵等抗病毒的感冒药治疗即可
前列腺理疗仪使用方法 基础操作